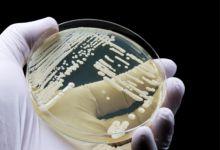

39 dakika önce
Göçmen teknesi alabora oldu: 70’ten fazla kişi kayıp
Akdeniz’i geçmeye çalışan düzensiz göçmenleri taşıyan bir teknenin alabora olması sonucunda 70’ten fazla kişinin denizde kaybolduğu belirtildi. Düzensiz göç rotaları…
4 saat önce
Güven Ekonominin Vazgeçilmezidir..
Ekonomi, güven üzerine kurulu görünmez bir sözleşmedir. Vatandaş ile devlet arasındaki bu sözleşmenin en kritik maddesi ise belirsizlik dönemlerinde sergilenen…
4 saat önce
Belki de Son Görüşme Olacak..!
Bir tahmin veya temenni değil. Sadece tarafların duruşlarının yarattığı duruma bakarak gördüğümü söylüyorum. Öncelikle Türk tarafından başlayalım. Kıbrıs Türk…
5 saat önce
Amerikan-İslam İlişkileri Konseyi, ABD Başkanı Trump’ın ifadelerini eleştirdi
Amerikan-İslam İlişkileri Konseyi, ABD Başkanı Donald Trump’ın, İran’ı tehdit ettiği bir sosyal medya paylaşımında kullandığı “Allah’a şükür” ifadesini eleştirerek, alaycı…
7 saat önce
Trump, İran’a anlaşma için tanıdığı süreyi 8 Nisan’a kadar uzattı
ABD Başkanı Donald Trump, Tahran yönetimine anlaşma yapmak için tanıdığı 48 saatlik süreyi 8 Nisan’a kadar uzattığını belirtti. Trump, sosyal…
10 saat önce
İran, Hürmüz Boğazı’nın açılması için savaş tazminatı talep etti
İran, Hürmüz Boğazı’nın “İran’a yönelik saldırıların meydana getirdiği zararın, yeni bir geçiş statüsü ile elde edilecek gelirin bir kısmıyla telafi…
10 saat önce
Erhürman ve Hristodulidis yarın bir araya gelecek
Lefkoşa, 5 Nisan 26 (TAK): Cumhurbaşkanı Tufan Erhürman ile Rum Yönetimi Başkanı Nikos Hristodulidis, yarın bir araya gelecek. Birleşmiş Milletler…
10 saat önce
LTB, 482 bin 898 euro tutarında yatırımla Sanayi Bölgesi’nin İçme Suyu Şebekesi’ni yeniliyor
Lefkoşa, 5 Nisan 26 (TAK): Lefkoşa Türk Belediyesi (LTB), altyapı çalışmalarını güçlendirmek ve kent genelinde içme suyu hizmetlerinin kalitesini artırmak…
10 saat önce
Serdaroğlu: “Yarın saat 09.30’da Lefkoşa Mor Çember noktasında toplanarak, Cumhuriyet Meclisi’ne yürüyeceğiz”
Lefkoşa, 5 Nisan 26 (TAK): Hür İşçi Sendikaları Federasyonu (Hür-İş) ve Kamu İşçileri Sendikası (Kamu-İş) Başkanı Ahmet Serdaroğlu, yarın genel…
10 saat önce
Atan’dan Meclis önüne yapılacak yürüyüşe katılım çağrısı
Lefkoşa, 5 Nisan 26 (TAK): Kıbrıs Türk Kamu Görevlileri Sendikası (KAMUSEN) Başkanı Metin Atan, sendikaların yarın genel grevde olacağını hatırlatarak,…